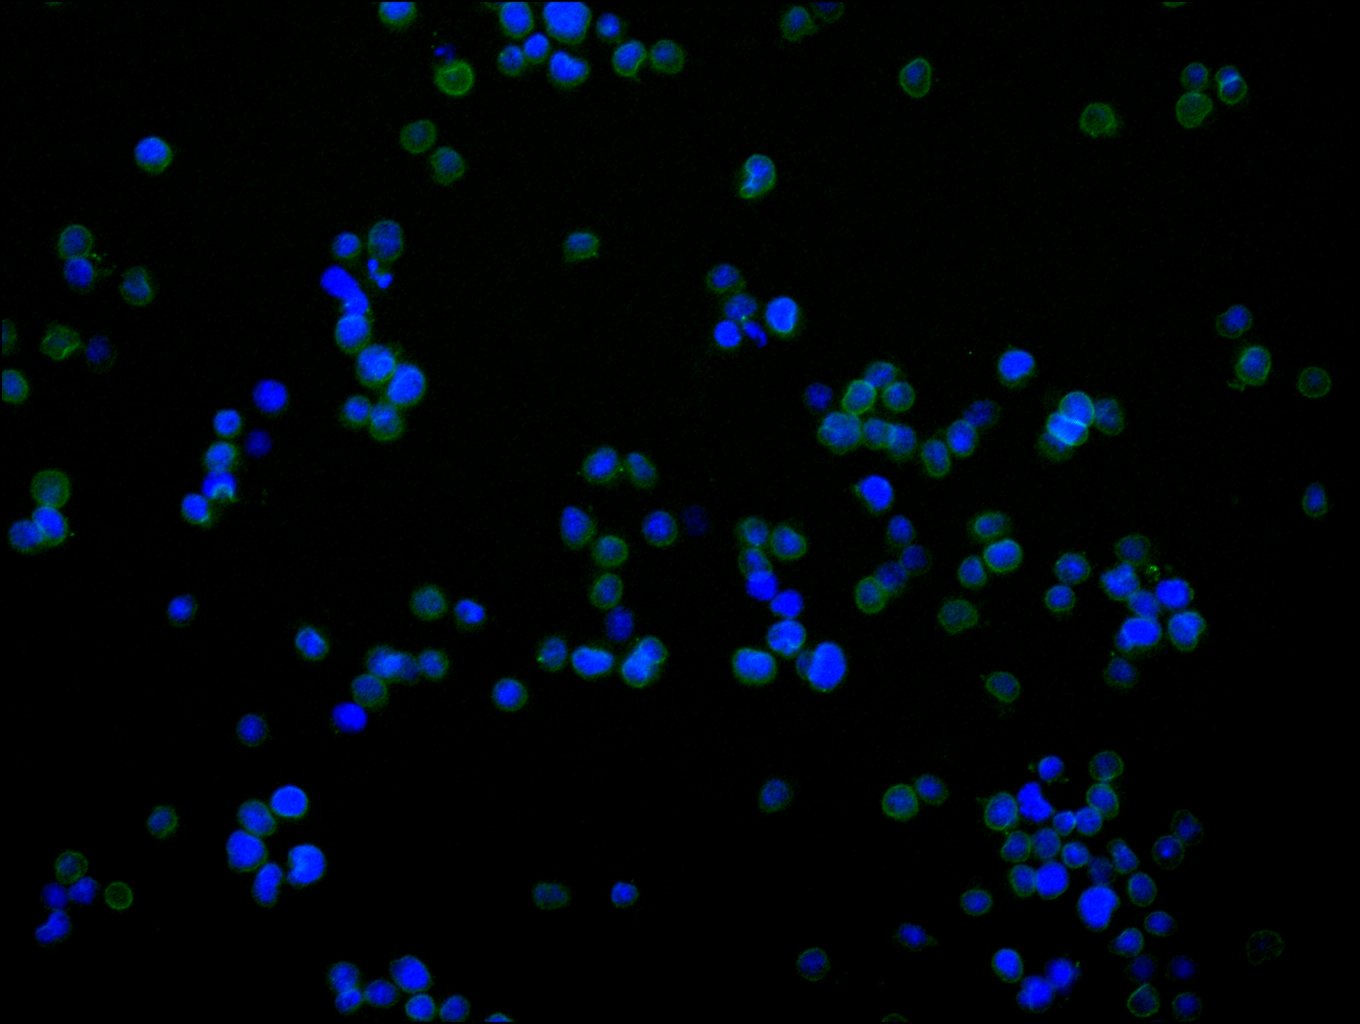

-
中文名稱:LMNB2 Recombinant Monoclonal Antibody
-
貨號:CSB-RA266964A0HU
-
規格:¥1320
-
圖片:
-
Western Blot
Positive WB detected in: HeLa whole cell lysate(30μg), THP-1 whole cell lysate, PC-3 whole cell lysate(30μg)
All lanes: LMNB2 antibody at 1:1000
Secondary
Goat polyclonal to rabbit IgG at 1/50000 dilution
Predicted band size: 70 kDa
Observed band size: 68 kDa
Exposure time: 3min -
IHC image of CSB-RA266964A0HU diluted at 1:100 and staining in paraffin-embedded human glioma cancer performed on a Leica BondTM system. After dewaxing and hydration, antigen retrieval was mediated by high pressure in a citrate buffer (pH 6.0). Section was blocked with 10% normal goat serum 30min at RT. Then primary antibody (1% BSA) was incubated at 4°C overnight. The primary is detected by a Goat anti-rabbit polymer IgG labeled by HRP and visualized using 0.05% DAB.
-
IHC image of CSB-RA266964A0HU diluted at 1:100 and staining in paraffin-embedded human kidney tissue performed on a Leica BondTM system. After dewaxing and hydration, antigen retrieval was mediated by high pressure in a citrate buffer (pH 6.0). Section was blocked with 10% normal goat serum 30min at RT. Then primary antibody (1% BSA) was incubated at 4°C overnight. The primary is detected by a Goat anti-rabbit polymer IgG labeled by HRP and visualized using 0.05% DAB.
-
Immunofluorescence staining of Jurkat cell with CSB-RA266964A0HU at 1:50, counter-stained with DAPI. The cells were fixed in 4% formaldehyde, permeabilized using 0.2% Triton X-100 and blocked in 10% normal Goat Serum. The cells were then incubated with the antibody overnight at 4°C. The secondary antibody was Alexa Fluor 488-congugated AffiniPure Goat Anti-Rabbit IgG(H+L).
-
Overlay Peak curve showing HepG2 cells stained with CSB-RA266964A0HU (red line) at 1:100. The cells were fixed in 4% formaldehyde and permeated by 0.2% TritonX-100 for 10min. Then 10% normal goat serum to block non-specific protein-protein interactions followed by the antibody (1ug/1*106cells) for 45min at 4℃. The secondary antibody used was FITC-conjugated goat anti-rabbit IgG (H+L) at 1/200 dilution for 35min at 4℃.Control antibody (green line) was Rabbit IgG (1ug/1*106cells) used under the same conditions. Acquisition of >10,000 events was performed.
-
-
其他:
產品詳情
-
Uniprot No.:
-
基因名:
-
別名:LAMB 2 antibody; LAMB2 antibody; Lamin-B2 antibody; LMN 2 antibody; LMN B2 antibody; LMN2 antibody; LMNB 2 antibody; LMNB2 antibody; LMNB2_HUMAN antibody; MGC2721 antibody; RGD1563803 antibody
-
反應種屬:Human
-
免疫原:A synthesized peptide derived from human LMNB2
-
免疫原種屬:Homo sapiens (Human)
-
標記方式:Non-conjugated
-
克隆類型:Monoclonal
-
抗體亞型:Rabbit IgG
-
純化方式:Affinity-chromatography
-
克隆號:15C5
-
濃度:It differs from different batches. Please contact us to confirm it.
-
保存緩沖液:Rabbit IgG in 10mM phosphate buffered saline , pH 7.4, 150mM sodium chloride, 0.05% BSA, 0.02% sodium azide and 50% glycerol.
-
產品提供形式:Liquid
-
應用范圍:ELISA, WB, IHC, IF, FC
-
推薦稀釋比:
Application Recommended Dilution WB 1:500-1:2000 IHC 1:50-1:200 IF 1:50-1:200 FC 1:50-1:200 -
Protocols:
-
儲存條件:Upon receipt, store at -20°C or -80°C. Avoid repeated freeze.
-
貨期:Basically, we can dispatch the products out in 1-3 working days after receiving your orders. Delivery time maybe differs from different purchasing way or location, please kindly consult your local distributors for specific delivery time.
-
用途:For Research Use Only. Not for use in diagnostic or therapeutic procedures.
相關產品
靶點詳情
-
功能:Lamins are components of the nuclear lamina, a fibrous layer on the nucleoplasmic side of the inner nuclear membrane, which is thought to provide a framework for the nuclear envelope and may also interact with chromatin.
-
基因功能參考文獻:
- our studies strongly implicate an overarching role for Lamin B2 in the maintenance of nuclear architecture since loss of Lamin B2 relieves the spatial positional constraints required for maintaining conserved localization of aneuploid chromosome territories in the interphase nucleus. PMID: 26921073
- Mutation of the nuclear lamin gene LMNB2 in progressive myoclonus epilepsy with early ataxia. PMID: 25954030
- Nuclear envelope remodelling during human spermiogenesis involves somatic B-type lamins and a spermatid-specific B3 lamin isoform. PMID: 25477337
- Treating normal human fibroblasts with farnesyltransferase inhibitors causes the accumulation of unprocessed lamin B2 and lamin A and a decrease in mature lamin B1 PMID: 23475125
- Mutation in LMNB2 gene is associated with partial lipodystrophy. PMID: 22768673
- Studies indicate that the lamin-binding proteins implicated in laminopathies include lamin B2 and nuclear envelope proteins. PMID: 21400569
- These findings indicate that a lamin dimer principally has the freedom for a "combinatorial" head-to-tail association with all types of lamins, a property that might be of significant importance for the assembly of the nuclear lamina. PMID: 20004208
- analysis of protein-DNA interactions at the human lamin B2 replication origin PMID: 12902329
- The proteins bound in vivo at the LMNB2 replication origin were investigated along the cell cycle. PMID: 12912926
- This analysis reveals the modular structure of the lamin B2 origin and supports the idea that sequence elements close to the replication start site play an important role in origin activation. PMID: 15024083
- the distinctive ensemble of heterotypic lamin interactions in a particular cell type affects the stability of the lamin polymer PMID: 15284226
- the lamin B2 origin adopts a structure partly composed of intramolecular TAT triads PMID: 15611042
- lamin B was essential for the formation of the mitotic matrix that tethers a number of spindle assembly factors; propose that lamin B is a structural component of the spindle matrix that promotes microtubule assembly and organization in mitosis PMID: 16543417
- Three new rare heterozygous mutations are the first reported for LMNB2 and are the first reported among patients with acquired partial lipodystrophy. PMID: 16826530
- human lamin B(2) is indeed synthesized as a longer version than previously reported, because it contains these additional 20 amino acids PMID: 17070523
- The human DNA replication origin, located in the lamin B2 gene, interacts with the DNA topoisomerases I and II in a cell cycle-modulated manner. PMID: 17290216
顯示更多
收起更多
-
相關疾?。?/div>Partial acquired lipodystrophy (APLD); Epilepsy, progressive myoclonic 9 (EPM9)亞細胞定位:Nucleus inner membrane; Lipid-anchor; Nucleoplasmic side.蛋白家族:Intermediate filament family數據庫鏈接:
Most popular with customers
-
-
YWHAB Recombinant Monoclonal Antibody
Applications: ELISA, WB, IHC, IF, FC
Species Reactivity: Human, Mouse, Rat
-
Phospho-YAP1 (S127) Recombinant Monoclonal Antibody
Applications: ELISA, WB, IHC
Species Reactivity: Human
-
-
-
-
-